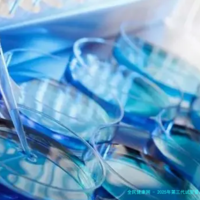

跟着现代辅助生育技术的快捷发展,越发越多的生育困难家庭开始注意助孕机构的选择。长沙作为湖南省省会,拥有诸多家能力较强的助孕机构,提供包括三代试管婴儿等优秀技术支持。本文单独个例的揭秘了湖南长沙助孕机构的前十强排名,深入分析各机构技术优势,帮助读者理清哪家技术更胜一筹,为助孕之路提供实在参考。
助孕机构综合实力评估
助孕机构的排行不仅仅依赖于某一方面的指标,而是综合了技术实力、专业人士集体、设备先决条件、服务质量及成功率等因素。长沙多家助孕机构具备开展代、第二代甚至第三代试管婴儿技术的资质,其中技术能力强、研发生殖技术优秀的机构通常居于排行前列。这一些机构不但拥有临床丰富的医生团队,还配备了优秀的胚胎培育、遗传筛查器械,确保每一步助孕过程科学谨严。
机构规模及经验积聚同样是评估确定的重要规范。临床成功多、病人惬意度高的机构,更能展现实际上力和服务水平。长沙商场上的前十强助孕机构,均有详实的治疗数据支持其排行靠前。

技术水平的关键指标
在很多技术中,第三代试管婴儿技术以其能够通过胚胎植入前基因诊断/检查筛选(PGD/PGS)有效筛除染色体异样,促进受孕成功率和胎儿健康水平而备受关注。长沙率先的助孕机构均能开展这个技术,其成功率可达到60%上述,表现了较高的技术门坎和临床本领。
技术先进还表现在促排卵方案个体化制订、胚胎培养环境改良及心理辅导等方面。助孕机构通过全流程数据监控和科学习分数析,来提高整体助孕成功率。对病患而言,拥有智能化、数据化设备的机构更值得信赖。
服务质量与患者体验
优质的助孕服务不但囊括技术实力,还体现如今细密的患者关怀和服务体会上。长沙排行靠前的助孕机构平常配备专业的心理医生,帮助病人缓解助孕过程当中的生理压力,提高治疗对峙度。
地舆座位的便捷性、预约流程的便利性、费用透明公开同样是病患选择的重要考量。机构完善的售后服务和持续追查管理,保障病人在治疗前后都能获取知心支持,构建优良的医生和患者关系。
综合费用与性价比分析
助孕过程涉及多项考试和治疗方法,费用加入不菲。排行靠前的长沙助孕机构虽在费用上略高,但凭借高成功率和全方位的服务体制,性能价格比比较合理。不同机构根据技术使用、器械投入及专家团体不同,收费也有差异。
合理估算和科学规划医治周期,关于把握整体助孕本钱特别首要。建议病人结合自身经济状况,与机构进行详细交流,抉择既契合技术需求又能承受费用的方案。
十大助孕机构综合排名展示
(下列以某某机构代称,避免侵权)
1. 某某机构:技术优秀,三代试管婴儿成功率位于前线,器械先进,专家团体力量雄厚。
2. 某某机构:格外关注繁杂病例,个体化促排方案取得优良效果。
3. 某某机构:注重病人心理咨询,全体服务体会优越。
4. 某某机构:拥有完备的数据管理体系,治疗阶段准确掌控。
5. 某某机构:价格适度,适宜百般破费档次。
6. 某某机构:备有丰富临床经验,擅长疑问不孕。
7. 某某机构:服务细致,重视患者全阶段跟踪。
8. 某某机构:地理位置优良,利便就诊。
9. 某某机构:新技术引进快,科研本事凸出。
10. 某某机构:信誉优秀,病患复诊率高。
怎么样选择适宜的助孕机构
抉择合适己方的助孕机构,应结合技术力量、服务素养和自我需求多维度考量。建议多咨询不同机构,认知治疗计划、成功率和费用细微之处。尤其是针对自我身体素质,选择备有针对性治疗能力的机构。留意机构的心理支持和服务立场,保障在漫长治疗过程中获取必需支持。
提升助孕成功率的建议
辅助生殖技术一日千里,病患应保持积极心态,严守医嘱。合理饮食、适度运动及良好心态有助提高成功率。选择技术优秀、服务殷勤的机构,可系统提高治疗成效。定期反应身体状况,与医疗护理团队坚持交流,科学调整诊疗方案。
【编辑:lexi】